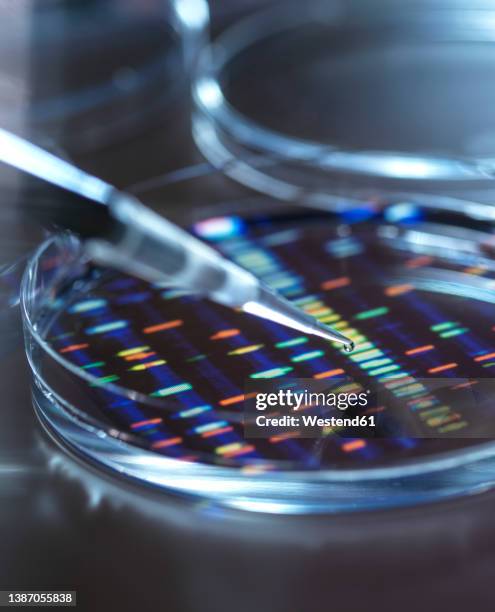
pipetting sample into tray for dna testing with result in background - scientific sample stock pictures, royalty-free photos & images

9,938 Scientific Sample Images and Stock Photos
View scientific sample videos
Browse 9,938 authentic scientific sample stock photos, high-res images, and pictures, or explore additional scientist or scotch whiskey stock images to find the right photo at the right size and resolution for your project.

of100NEXT